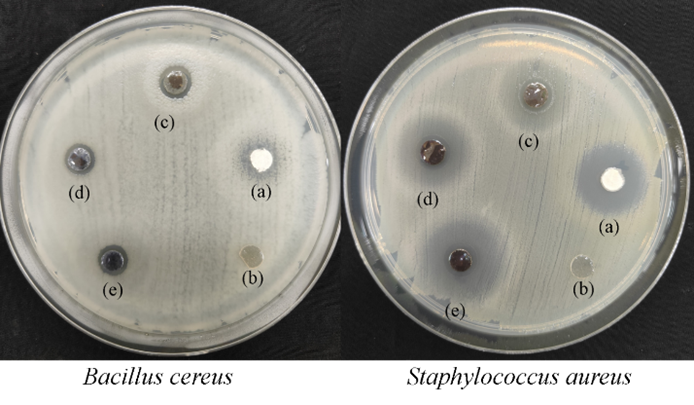

Trends
Sci.
2025;
22(10):
10418
Antibacterial Hydrogel Films Embedded with Cu–Ag Oxide Nanoparticles Based on Basil Seed Mucilage for Advanced Wound Dressing Applications
Jiyapa Sripirom1, Rungrudee Srisomang1, Sakuntala Siri-Udom2,
Cybelle Morales Futalan3, Khongvit Prasitnok4, Orrasa Prasitnok4, Sirilak Kamonwannasit5,
Agarat Kamcharoen5, Pongtanawat Khemthong6 and Piaw Phatai1,*
1Department of Chemistry, Faculty of Science, Udon Thani Rajabhat University, Udon Thani 41000, Thailand
2Department of Biology, Faculty of Science, Udon Thani Rajabhat University, Udon Thani 41000, Thailand
3Institute of Civil Engineering, University of the Philippines Diliman, Quezon City 1101, Philippines
4Department of Chemistry, Faculty of Science, Mahasarakham University, Maha Sarakham 44150, Thailand
5Department of Agro-Industrial Product Development, Faculty of Agricultural Technology, Burapha University,
Sakaeo 27160, Thailand
6National Nanotechnology Center (NANOTEC), National Science and Technology Development Agency (NSTDA), Pathum Thani 12120, Thailand
(*Corresponding author’s e-mail: [email protected])
Received: 21 April 2025, Revised: 26 May 2025, Accepted: 5 June 2025, Published: 15 July 2025
Abstract
Hydrogel
films with antibacterial properties, swelling capability, and
mechanical strength show promise as wound dressings. This study
investigates the fabrication of Cu1.0-xAgₓO
(x = 0.0, 0.1, 0.5, 0.9, and 1.0) antibacterial nanoparticles loaded
into basil seed mucilage (BSM)/hydrogel (BSM/HG) films via a casting
method. The crystal phases, surface chemical composition, and
antimicrobial efficacy of Cu1.0-xAgₓO
particles were characterized using X-ray diffraction (XRD), X-ray
photoemission spectroscopy (XPS), and agar well diffusion assays. XRD
analysis confirmed that
Cu1.0-xAgₓO
(x = 0.1 – 0.7) samples formed composites containing CuO, Ag, and
Ag2O
phases. Among them, Cu0.7Ag0.3O
exhibited superior antibacterial activity, achieving inhibition zone
diameters of 8
13 mm against Bacillus
cereus,
Staphylococcus
aureus,
Streptococcus
thermophilus,
and Escherichia
coli.
The hydrogel demonstrated good swelling capacity and mechanical
strength suitable for wound dressing applications. The incorporation
of Cu0.7Ag0.3O
nanoparticles into BSM/HG films reduced both swelling capacity and
tensile strength due to particle agglomeration, although the
antibacterial properties were significantly enhanced. This research
highlights the potential of Cu1.0-xAgₓO-loaded
BSM/HG films for advanced wound dressing applications.
Keywords: Alginate, Antibacterial activity, Basil seed mucilage, Composite material, Copper-silver oxide, Gelatin, Hydrogel film
Introduction
Hydrogels are highly hydrated materials composed of hydrophilic polymers with networks of chemical and/or physical crosslinks between macromolecular chains [1,2]. They are used in various fields, including sensors, biomaterials, drug delivery, water treatment, tissue engineering, and soft electronics [3-7]. In wound care, hydrogels offer several advantages: they absorb exudates, maintain a moist environment, are easy to remove, and are biocompatible and safe [1,2].
Several benchmark studies have demonstrated the potential of hydrogel-based wound dressings to enhance healing rates, reduce infection, and promote tissue regeneration [8,9]. Recent advances have explored the integration of cell-derived conditioned media (CM) into hydrogel matrices, demonstrating enhanced angiogenesis and accelerated wound repair [8]. Additionally, the development of biopolymer-based smart hydrogels that respond to wound-specific stimuli has shown significant potential in overcoming limitations of traditional dressings [9]. Hydrogels can be synthesized from natural, synthetic, or hybrid polymers [10,11]. Natural polymers like alginate, gelatin, collagen, and chitosan are commonly used, while synthetic polymers include PEG, PEO, PVA, and polypeptides. However, their weak mechanical strength limits traditional hydrogel applications [12].To address this, recent developments include dual cross-linked, double network, and topological hydrogels [13,14]. Tougher hydrogels based on cellulose, chitosan, alginate, and gelatin have been explored [15]. Gelatin (G), a denatured collagen, crosslinks easily and is widely used for its biocompatibility and biodegradability. Sodium alginate (SA) is a polyanionic copolymer that forms gels via ionic interactions with divalent or trivalent cations like Ca2+, Cu2⁺, Ba2⁺, and Fe3⁺. Though alginate has useful properties, it lacks biological activity and is often blended with gelatin to improve hydrogel characteristics [16]. For example, Saarai et al. [16] found that a 50:50 SA:G hydrogel crosslinked with Ca2⁺ offered optimal mechanical and swelling behavior. However, monovalent salts can destabilize SA-Ca2⁺ interactions. Yari et al. [17] enhanced SA hydrogel stability using basil seed mucilage (BSM). BSM, derived from Ocimum basilicum L., contains glucomannan, xylan, and uronic acid, offering excellent water absorption [18,19]. It serves as a food stabilizer and was used here to enhance hydrogel strength and swelling [20]. Nanomaterials such as graphene oxide Jing et al. [21], silica Mohammed et al. [22], ZnO/CuO Kaptan et al. [23], and Ag Martinez-Higuera et al. [24] have also been integrated into hydrogels to boost antibacterial activity.
In
this study, Cu1.0-xAgₓO
nanoparticles
and BSM were incorporated into hydrogel films and evaluated for
antibacterial activity, swelling, and mechanical performance. While
several studies have incorporated metal oxide nanoparticles into
biopolymer-based hydrogels for wound healing, most have focused on
well-known polymers such as chitosan, alginate, or gelatin, and
single oxide systems like CuO or Ag2O.
In contrast, this study introduces a novel strategy by utilizing
basil seed mucilage (BSM)—a natural, underutilized, and highly
swellable polysaccharide—as the hydrogel-forming matrix.
Additionally, the
Cu1.0-xAgₓO
(0.1
≤ x ≤ 0.7) nanoparticles represent a tunable mixed metal oxide
system that leverages the synergistic antibacterial properties of
CuO, Ag, and Ag2O
phases within a single nanocomposite. This approach enables
composition-dependent control over antibacterial efficacy and
mechanical performance, distinguishing it from previous studies
using simple metal oxide blends. To the best of our knowledge, the
combination of BSM-based hydrogels with compositional tuning of
Cu–Ag oxide nanoparticles has not yet been reported for wound
dressing applications, making this study a unique contribution to
the development of multifunctional hydrogel material
Materials and methods
Materials
All chemicals were of analytical grade and used without further purification. Deionized water was used throughout. Cu1.0-xAgₓO (x = 0.0, 0.1, 0.5, 0.9 and 1.0) was synthesized using Cu(NO3)2, AgNO3, NaOH, PEG-4000, and NH3. Hydrogel materials included sodium alginate, gelatin, glycerol, PEG-6000, NaCl, and CaCl2. Basil seeds were sourced from a local market in Udon Thani, Thailand. Antimicrobial activity was tested against Bacillus cereus, Streptococcus thermophilus, Staphylococcus aureus, Escherichia coli, Fusarium oxysporum, and Penicillium sp. The selected bacterial strains, including Gram-positive (S. aureus, B. cereus) and Gram-negative (E. coli, S. thermophilus), are clinically relevant pathogens frequently implicated in wound infections. Their inclusion allows for evaluating the broad-spectrum antibacterial potential of the hydrogel composites. Microbial strains were maintained on nutrient agar slants.
Synthesis of Cu1.0-xAgxO composite
Cu1.0-xAgxO was synthesized using a co‑precipitation method modified from our previous work [25]. First, Cu(NO3)2, AgNO3 and PEG-4000 were individually dissolved in DI water under constant stirring for 15 min. Next, the solution pH was adjusted to 12.0 0.2 using a 1.5 M NaOH solution. Subsequently, the mixed solution was stirred vigorously for 30 min until dark precipitates were obtained. After that, the precipitates were filtered using Whatman No. 93 filter paper and washed repeatedly with DI water. Then, the obtained particles were oven dried at 110 °C for 5 h and calcined at 600 °C for 4 h. For simplification, Cu1.0-xAgxO where x = 0.0, 0.1, 0.3, 0.5, 0.7 and 0.9 are referenced as Cu1.0O, Cu0.9Ag0.1O, Cu0.7Ag0.3O, Cu0.5Ag0.5O, Cu0.3Ag0.7O and Cu0.1Ag0.9O, respectively. XRD, XPS and antimicrobial activities of the nanocomposites were further investigated. The term "CuAgO" is used solely as a general abbreviation when referring to the composite group. The highest antimicrobial activity from Cu1.0‑xAgxO (Cu0.7Ag0.3O), was used in fabrication of a Cu0.7Ag0.3O-loaded hydrogel film.
Preparation of BSM from basil seeds
BSM was prepared using a hydration method. First, 10 g of basil seeds were soaked in 300 mL of DI water at 40 °C for 1 h. Next, the swollen seeds were broken in a blender for 1 min and then filtered using cheese cloth. After that, the mucilage was centrifuged at 5000 rpm for 5 min to remove seed residues. Then, the BSM mucilage was oven dried at 50 °C for 24 h. Finally, brown particles of BSM were obtained and kept in a desiccator.
Preparation of BSM/HG and Cu0.7Ag0.3O-loaded BSM/HG
Hydrogel
films with BSM concentrations of
0.0
– 0.9
%w/v
were prepared following Saarai
et
al.
[16]
with slight modifications.
Dried
BSM was soaked in 200 mL DI water at 80 °C.
Alginate
(2.0%
w/v),
gelatin (2.0
%w/v),
glycerol (2.0
%w/v),
PEG-6000
(1.0
%w/v),
and NaCl (0.2%
w/v)
were
added and stirred for 30 min.
The
gel was cast onto a 25.4×25.4×0.2
cm aluminum plate and dried for 1 h.
A
5.0
%w/v
CaCl2
solution
was added for 15 min.
Films
were washed and labeled as HG, 0.1BSM/HG
to 0.9BSM/HG.
Mechanical
and swelling properties were evaluated.
Cu0.7Ag0.3O loaded BSM/HG was prepared in a manner similar to BSM/HG. Cu0.7Ag0.3O particles with concentrations of 3.75, 7.50 and 15.0 mg/mL were added to the 0.5 %w/v BSM solution. Then, alginate, gelatin, glycerol, PEG-6000 and NaCl were added to the mixture. Hydrogel films with different concentrations (0.00, 3.75, 7.50 and 15.0 mg/mL) of Cu0.7Ag0.3O are referenced as BSM/HG, 3.75Cu0.7Ag0.3O/BSM/HG, 7.50Cu0.7Ag0.3O/BSM/HG and 15.0Cu0.7Ag0.3O/BSM/HG, respectively.
Characterization techniques
The
crystal structure of CuAgO
particles was analyzed by X-ray
diffraction (XRD,
Bruker D8 Advance)
using
Cu Kα radiation (λ
=
1.54184
Å),
a 2θ range of 20°
– 80°,
40 mA current, and 40 kV voltage.
The
chemical surface composition was examined by
X-ray
photoemission spectroscopy (XPS,
Kratos Axis Ultra DLD)
with
monochromatic Al Kα radiation
(10
mA, 35 kV)
under
a chamber pressure of 3×10⁻9
Torr.
The
C 1s peak at 285.0
eV was used for calibration, and Cu 2p, Ag 3d, and O 1s peaks were
analyzed using a Lorentzian-Gaussian
function.
Functional
groups of Cu0.7Ag0.3O/BSM/HG
were identified via attenuated total reflectance Fourier-transform
infrared spectroscopy (ATR/FT-IR,
Spectrum 2, PerkinElmer)
in
the 4000
– 500
cm⁻1
range at 4 cm⁻1
resolution.
Surface
morphology and elemental composition were observed using SEM-EDX
(Hitachi
S 3000N, 5 kV).
Films
were gold-coated
with a K500X sputter coater (20
mA, 5 min, 9×10⁻²
mbar)
before
SEM analysis.
Swelling tests
To determine the degree of swelling of the film samples, pre-weighed dried 1.0 1.0 cm film samples (W1) were immersed in phosphate buffer (pH 7.4) at room temperature. The swollen films were removed after various immersion times, wiped with tissue paper to remove excess surface fluid and weighed (W2). The percentage swelling ratio (SR, %) was computed after each time as follows:

Tensile properties
Tensile strength and elongation at break of BSM/HG films were measured using a Universal Testing Machine (GT-K01-GESTER) according to SATRA TM5 and ISO 20344 standard. Film strips (1.5×10.0 cm) were tested at a crosshead speed of 20 mm/min using a 50 mm gauge length and 5 kN load cell. All measurements were performed in 5 replicates (n = 5), and the results are reported as mean ± standard deviation.
Antimicrobial activity
The antibacterial and antifungal activities of CuAgO composites were evaluated using the agar well diffusion method. Bacterial strains (Bacillus cereus, Staphylococcus aureus, Streptococcus thermophilus, and Escherichia coli) were cultured in Mueller-Hinton broth (MHB) for 18 h at 37 °C with a 0.5 McFarland standard turbidity. Then, 100 µL of each suspension was spread on MHB agar plates. Wells (6 mm diameter) were created using a sterile cork borer, and 30 µL of CuAgO was added to each. Plates were incubated at 37 °C for 24 h. Tetracycline (50 µg) and dimethyl sulfoxide (DMSO) served as positive and negative controls. Inhibition zones were measured with a micrometer. Antifungal activity against Fusarium oxysporum and Penicillium sp. was tested similarly, using nystatin as a positive control. Antibacterial activity of BSM/HG and Cu0.7Ag0.3O/BSM/HG films was tested by disc diffusion. Films (6 mm) and filter paper discs were placed on agar plates and incubated at 37 °C for 24 h.
All experiments for swelling tests and antibacterial activity were conducted in triplicate (n = 3). Results are presented as mean ± standard deviation. Statistical analysis was performed using one-way ANOVA to assess differences between groups.
Determination of minimum inhibition concentration (MIC)
The minimum inhibitory concentration (MIC) is defined as the lowest concentration of a substance that completely inhibits visible bacterial growth after incubation at 37 °C for 24 h. In this study, the MIC values of Cu0.5Ag0.5O and Cu0.7Ag0.3O against Staphylococcus aureus, Bacillus cereus, and Escherichia coli using a broth dilution method based on the protocol described by Kamonwannasit et al. [26]. Bacterial suspensions were prepared at a concentration of 1 × 10⁷ CFU/mL in Mueller-Hinton Broth (MHB). CuAgO samples were serially diluted to obtain a range of concentrations from 0.47 to 30.00 mg/L. The inoculated tubes was incubated at 37 °C for 24 h, and the MIC was recorded as the lowest concentration showing no visible bacterial growth. All experiments were conducted in triplicate to ensure reproducibility and accuracy of the results.
Results and discussion
XRD and XPS analysis
The
crystal structure of CuAgO
samples with different compositions calcined at 600 °C for
4
h is shown in Figure
1.
The
XRD patterns and their corresponding lattice planes of CuO in a
Cu1.0O
sample were observed at 2
= 35.78o
(
111),
38.89o
(111),
48.92o
(
202),
53.69o
(020),
58.46o
(202),
61.68o
(
113),
66.47o
(022),
68.37o
(220),
72.79o
(311)
and
75.41o
(004)
(JCPDS
No.
45-0937).
This
indicates a typical CuO monoclinic structure within the C2/c
space group.
CuO,
Ag and Ag2O
phases were detected in
Cu1.0-xAgxO
(x
=
0.1
- 0.7)
samples.
This
indicates that a CuAgO composite was formed.
An
Ag2O
phase was observed at 2
= 38.40o
(011)
that
corresponds to the hexagonal structure of silver oxide within the
P3m1
space group (JCPDS
No.
72-2108).
Metallic
Ag was also found at 2
= 38.40o
(111),
44.63o
(200),
64.79o
(220)
and
77.56o
(311),
which implies the presence of the face centered cubic crystalline
structure of silver within the Fm3m
space group (JCPDS
No.
04-0783).
Detection
of a CuO phase was impossible due to the very small fraction of
copper in Cu0.1Ag0.9O
samples.
XPS analysis was conducted to confirm the XRD results. This technique is normally used to identify the elements present on the surface of a specimen, as well as the valence states and interactions of each atom. Figure 2 displays the XPS spectra of O 1s, Cu 2p and Ag 3d core levels from the Cu0.7Ag0.3O sample. In Cu 2p spectra (Figure 2(a)), characteristic double peaks at 952.72 and 932.93 eV correspond to Cu 2p1/2 and Cu 2p3/2, respectively. The 19.8 eV energy gap between these levels is due to spin-orbit coupling and is in good agreement with the literature values [27-30]. Additionally, 2 bands at 942.46 and 961.02 eV can be ascribed to the shake-up satellite peaks of Cu2+ in CuO with d9 configuration in its ground state. Therefore, the appearance of the satellite peaks indicates the presence of the CuO species in the surface layer.
The
XPS spectrum of Ag 3d (Figure
2(b))
reveals
2 peaks at 373.87
and 367.99
eV with an energy gap of 5.88
eV (spin-orbit
splitting)
indicating
Ag 3d3/2
and Ag 3d5/2,
respectively.
This
suggests formation of metallic silver (Ag0)
in
the composite.
Moreover,
the Ag 3d3/2
and Ag 3d5/2
core levels shift towards lower binding energies, 373.01
and 367.29
eV, respectively.
This
is due to the presence of silver ions in Ag2O
(Ag+),
in agreement with the literature [31,32].
The
presence of 53
%
metallic
Ag relative to the amount of Ag2O
is also in agreement with XRD results.
The
XPS spectrum of
O 1s (Figure
2(c))
shows
3 peaks at 529.23,
531.67
and 533.14
eV.
The
peak centered at 529.23
eV corresponds to the O 1s of Cu O
or Ag O
in the form of CuO and Ag2O.
The
peaks at 531.67
and 533.14
eV correspond to oxygen adsorbed on the composite surface
[28,32].

Figure 1 XRD patterns of CuAgO composites calcined at 600 °C for 4 h.

Figure 2 (a) Cu 2p, (b) Ag 3d and (c) O 1s XPS spectra of Cu0.7Ag0.3O composite calcined at 600 °C for 4 h.
Antimicrobial activity of CuAgO composites
The
antibacterial activity of CuAgO
at a concentration of 30 mg/mL
against 4 bacterial strains was evaluated using an agar well
diffusion technique.
Table
1
shows the inhibition diameter around wells with CuAgO
particles against bacterial strains after 24 h of incubation.
A
larger diameter of inhibition indicates greater antibacterial
activity.
As
expected, the DMSO negative control was ineffective against all
bacterial strains, while tetracycline (50 g/mL),
a positive control, was effective with inhibition diameters of
11
29 mm.
No
strains were inhibited by the Cu1.0O
sample at a 30 mg/mL
concentration.
Inhibition
zones of Cu0.3Ag0.7O,
Cu0.5Ag0.5O,
Cu0.7Ag0.3O
and Cu0.9Ag0.1O
samples developed inhibition widths ranging from
8
13 mm for all bacterial strains.
Moreover,
the Gram-negative
bacterial strain, Escherichia
coli,
was only affected by the Cu0.1Ag0.9O
sample with an inhibition diameter of 7.0
mm.
These
results show that Gram-positive
and Gram-negative
bacteria had similar susceptibility.
MIC, a parameter indicating inhibitory efficacy, refers to the lowest concentration of an antibacterial reagent that will prevent bacterial growth after 24 h of incubation. Cu0.5Ag0.5O and Cu0.7Ag0.3O samples were chosen to determine the MIC values against Staphylococcus aureus, Bacillus cereus and Escherichia coli. The results are shown in Table 2. A MIC of 3.75 mg/mL against Escherichia coli was obtained for the Cu0.7Ag0.3O sample, while higher MIC values were observed against Bacillus cereus (7.5 mg/mL) and Staphylococcus aureus (15.0 mg/mL). For the Cu0.5Ag0.5O sample, the lowest MIC value, 0.94 mg/mL, was obtained against Bacillus cereus, while a MIC value of 15 mg/mL was found against Escherichia coli and Staphylococcus aureus. The present study revealed that the Cu0.7Ag0.3O sample had the optimal Cu:Ag molar ratio, 0.7:0.3, for antibacterial activity. This composition was used in subsequent fabrication of Cu0.7Ag0.3O/BSM/HG films. Moreover, antifungal activities of all CuAgO composites were investigated against Fusarium oxysporum and Penicillium sp. These results are shown in Table 1. Nystatin (50 g/mL) was effective against Fusarium oxysporum and Penicillium sp. with inhibition zones of 2.30 and 1.50 mm, respectively. No CuAgO samples were effective against any of the fungal strains tested at 30 mg/mL.
Swelling properties of BSM/HG film
The swelling ratio of hydrogel films is used for measuring their fluid absorbing capacities, which is particularly useful for wound dressing materials. These results are shown in Figure 3. The swelling ratio of HG and 0.1BSM/HG increased gradually with time (Figure 3(A)). For 0.3BSM/HG and 0.5BSM/HG samples, the swelling ratio of the film increased sharply until 120 min of immersion in a buffer solution, and then started to decrease. The decreased swelling ratio is due to dissolution of alginate in the aqueous medium. Extension of the SA chains causes breakdown of the crosslinking bonds in the presence of phosphate anion in the buffer [33]. Thus, a portion of SA may dissolve in PBS medium, resulting in a decreased polymer mass. For 0.7BSM/HG and 0.9BSM/HG samples, the swelling ratio of the films showed similar trends where it rises quickly in the first 90 min, and then slowly increased until 240 min of immersion. After 120 min of immersion (Figure 3(B)), neat HG films exhibited a swelling ratio of 1442 %. Greater BSM filler, up to 0.5 %w/v, increased the film swelling ratio. The 0.5BSM/HG specimen exhibited a 2102 % maximal swelling ratio. Notably, this was higher than that of a commercial sodium alginate hydrogel film (50 1800 %) [34]. Among the tested films, the 0.7BSM/HG and 0.9BSM/HG films showed low swelling ratios, which was presumably due to agglomeration of BSM particles.
Tensile properties of BSM/HG films
Generally, hydrogel films used as wound dressings need better mechanical properties because the wound surface will change with body movements. The mechanical properties of HG and BSM/HG films are shown in Figure 4.
Table 1 Antimicrobial activities of synthesized CuAgO samples against 4 different bacterial and fungal strains.
Type of bacteria/Fungi |
Inhibition diameter (mm) |
Tetracycline (50 g/mL) |
Nystatin (50 g/mL) |
(30 mg/mL) |
|||
Cu0.9Ag0.1O |
|
|
|
Bacillus cereus |
9.00 ± 1.40 |
|
|
Staphylococcus aureus |
12.00 ± 0.00 |
|
|
Streptococcus thermophilus |
10.30 ± 0.60 |
|
|
Escherichia coli |
9.30 ± 1.20 |
|
|
Fusarium oxysporum |
ND |
|
|
Penicillium sp. |
ND |
|
|
Cu0.7Ag0.3O |
|
|
|
Bacillus cereus |
8.50 ± 0.70 |
|
|
Staphylococcus aureus |
12.70 ± 3.20 |
|
|
Streptococcus thermophilus |
11.00 ± 1.00 |
|
|
Escherichia coli |
9.70 ± 0.60 |
|
|
Fusarium oxysporum |
ND |
|
|
Penicillium sp. |
ND |
|
|
Cu0.5Ag0.5O |
|
|
|
Bacillus cereus |
10.00 ± 0.00 |
|
|
Staphylococcus aureus |
8.30 ± 0.60 |
|
|
Streptococcus thermophilus |
11.30 ± 0.60 |
|
|
Escherichia coli |
9.70 ± 0.60 |
|
|
Fusarium oxysporum |
ND |
|
|
Penicillium sp. |
ND |
|
|
Cu0.3Ag0.7O |
|
|
|
Bacillus cereus |
9.00 ± 0.00 |
|
|
Staphylococcus aureus |
9.00 ± 0.00 |
|
|
Streptococcus thermophilus |
* |
|
|
Escherichia coli |
8.00 ± 0.00 |
|
|
Fusarium oxysporum |
ND |
|
|
Penicillium sp. |
ND |
|
|
Cu0.1Ag0.9O |
|
|
|
Bacillus cereus |
ND |
|
|
Staphylococcus aureus |
ND |
|
|
Streptococcus thermophilus |
* |
|
|
Escherichia coli |
7.00 ± 0.00 |
|
|
Fusarium oxysporum |
ND |
|
|
Penicillium sp. |
ND |
|
|
Cu1.0O |
|
|
|
Bacillus cereus |
ND |
|
|
Staphylococcus aureus |
ND |
|
|
Streptococcus thermophilus |
ND |
|
|
Escherichia coli |
ND |
|
|
Fusarium oxysporum |
ND |
|
|
Penicillium sp. |
ND |
|
|
Tetracycline |
|
|
|
Bacillus cereus |
|
17.70 ± 0.60 |
|
Staphylococcus aureus |
|
28.30 ± 5.70 |
|
Streptococcus thermophilus |
|
11.00 ± 1.00 |
|
Escherichia coli |
|
18.00 ± 1.00 |
|
Nystatin |
|
|
|
Fusarium oxysporum |
|
|
2.30 ± 0.10 |
Penicillium sp. |
|
|
1.50 ± 0.00 |
ND = not detected; * not tested |
|||
Table 2 MIC of Cu0.5Ag0.5O and Cu0.7Ag0.3O against Bacillus cereus, Staphylococcus aureus and Escherichia coli.
Type of bacteria |
MIC (mg/mL) |
|
Cu0.7Ag0.3O |
Cu0.5Ag0.5O |
|
Bacillus cereus |
7.50 |
0.94 |
Staphylococcus aureus |
15.0 |
15.0 |
Escherichia coli |
3.75 |
15.0 |

Figure 4 Tensile properties of HG, 0.1BSM/HG, 0.3BSM/HG, 0.5BSM/HG, 0.7BSM/HG and 0.9BSM/HG.
Stress-at-break and elongation-at-break of pure HG film were 16 MPa and 37%, respectively. The tensile stress of BSM/HG films increased with BSM content up to 0.5% w/v BSM (31 MPa), and then decreased with increasing amounts of BSM. Dispersion of BSM particles in the HG is important since uniformly dispersed BSM enhances the mechanical properties of a hydrogel. However, additional increases in BSM content cause formation of excessive numbers of BSM particles and subsequent accumulation. Moreover, the elongation-at-break of BSM/HG tended to decrease relative to the amount of BSM present, related to increased tensile stress. Since the 0.5BSM/HG film sample gave better swelling and mechanical properties than other samples, it was used for incorporation with Cu0.7Ag0.3O particles, which showed the highest antibacterial activity.
SEM-EDX and FT-IR analysis of Cu0.7Ag0.3O/BSM/HG films
SEM images of BSM/HG and 7.5Cu0.7Ag0.3O/BSM/HG films with a 5000 magnification are presented in Figure 5. The morphology of the pure HG film was rough with a non-porous structure (Figure 5(a)). For BSM/HG films with various concentrations of BSM, film roughness increases with BSM content (Figures 5(b) - (d)), particularly in 0.7BSM/HG (Figure 5(c)) and 0.9BSM/HG (Figure 5(f)) samples. This could be due to agglomeration of BSM particles. The 0.5BSM/HG film sample seems to have the best composition with smooth and non-porous surfaces, indicating a good distribution of BSM particles in the hydrogel matrix. Moreover, SEM imagery of the Cu0.7Ag0.3O/BSM/HG film (Figure 5(g)) showed rough and non-porous surfaces. However, Cu0.7Ag0.3O particles were not observed using this technique.
Elemental distribution of Ag and Cu in the 7.5 Cu0.7Ag0.3O/BSM/HG film was analyzed using EDS mapping. These results are shown in Figure 6, where Cu and Ag particles in the hydrogel matrix were homogeneously distributed. Moreover, the major constituents of 7.5 Cu0.7Ag0.3O loaded BSM/HG films were C, O, Cl and Ca. The presence of C may be due to the carbon tape used on the SEM stub during analysis as well as substances incorporated in the hydrogel films (PEG, sodium alginate, gelatin, BSM). Trace amounts of Na in the samples are due to NaCl used in the preparation of hydrogel film. Trace amounts of Cu and Ag were also detected.

Figure 5 SEM imagery of (a) HG, (b) 0.1BSM/HG, (c) 0.5BSM/HG, (d) 0.7BSM/HG, (e) 0.9BSM/HG and (f) 7.5 Cu0.7Ag0.3O/BSM/HG.

Figure 6 EDS mapping displays distribution of Ag and Cu elements in 7.5 Cu0.7Ag0.3O/BSM/HG: (a) secondary electron image, (b) the element sensitive map of combined Cu and Ag, (c) the element sensitive map of Ag, (d) the element sensitive map of Cu, and (e) EDS spectrum of 7.5Cu0.7Ag0.3O/BSM/HG
Figure 7 shows the FT-IR spectra of a Cu0.7Ag0.3O/BSM/HG film. The peaks of all samples are less distinct. The broad peaks between 3000 and 3600 cm-1, and 1626 cm-1 correspond to stretching and bending vibrations of the hydroxyl (OH-) groups of alginate, gelatin, BSM and PEG. The small peak at 2915 cm-1 is attributed to C H stretching. Peaks at 1640 and 1539 cm-1 can be ascribed to the C=O and C N stretching vibration of gelatin. Bands at 1640, 1435 and 1038 cm-1 indicate C OO asymmetric stretching vibrations of free carboxylate, C OO symmetric stretching, and C O C stretching of BSM and alginate, respectively [18,35].
Swelling and tensile properties of Cu0.7Ag0.3O/BSM/HG films
The swelling ratio of the Cu0.7Ag0.3O/BSM/HG film is shown in Figure 8(A). The swelling ratio of BSM/HG was 2102 %. In Cu0.7Ag0.3O loaded HG, the swelling ratios of all samples decreased approximately fourfold compared to that of BSM/HG. This decreased swelling capacity is presumably due to weakened mechanical interactions between the Cu0.7Ag0.3O particles and the hydrogel matrix, as well as nanoparticle agglomeration. Cu0.7Ag0.3O particles can occupy the mesh space or pore volume within the gel network, thereby hindering diffusion and penetration into the matrix [36]. Although high-resolution SEM or image-based analysis was not performed in this work, similar observations and interpretations have been reported in previous studies [36,37].
Tensile strength and elongation of Cu0.7Ag0.3O loaded BSM/HG are present in Figure 8(B). The tensile stress and elongation of BSM/HG were 31 MPa and 16 %, respectively. In Cu0.7Ag0.3O loaded BSM/HG, tensile stress and elongation were clearly low. These decreased swelling and mechanical properties of Cu0.7Ag0.3O loaded BSM/HG could be due to agglomeration and increased inhomogeneity of Cu0.7Ag0.3O particles. Lack of interfacial adhesion between the polymer matrix and oxide particles caused decreased tensile strength and swelling capacity [38].
Antibacterial activity of Cu0.7Ag0.3O-loaded BSM/HG films
The antibacterial activities of Cu0.7Ag0.3O (3.75, 7.50 and 15.0 mg/mL) loaded BSM/HG films against Staphylococcus aureus and Bacillus cereus were investigated using a disc diffusion method. These results are shown in Figure 9 and Table 3.

Figure 7 FT-IR spectra of (a) Cu0.7Ag0.3O, (b) 0.5BSM/HG, (c) 3.75Cu0.7Ag0.3O/BSM/HG, (d) 7.50Cu0.7Ag0.3O/BSM/HG and (e) 15.0Cu0.7Ag0.3O/BSM/HG.

Figure 8 (A) Swelling, and (B) tensile properties of Cu0.7Ag0.3O/BSM/HG.
Figure 9 Imagery of the antibacterial activity of Cu0.7Ag0.3O/BSM/HG against Bacillus cereus and Staphylococcus aureus: (a) Positive control, (b) BSM/HG, (c) 3.75Cu0.7Ag0.3O/BSM/HG, (d) 7.50Cu0.7Ag0.3O/BSM/HG and (e) 15.0 Cu0.7Ag0.3O/BSM/HG.
Table 3 Antibacterial activity of Cu0.7Ag0.3O/BSM/HG samples against Bacillus cereus and Staphylococcus aureus.
Type of bacteria |
Inhibition diameter (mm) |
Tetracycline (50 g/mL) |
3.75Cu0.7Ag0.3O/BSM/HG |
|
|
Bacillus cereus |
9.33 0.06 |
|
Staphylococcus aureus |
18.00 0.00 |
|
7.50Cu0.7Ag0.3O/BSM/HG |
|
|
Bacillus cereus |
8.67 0.06 |
|
Staphylococcus aureus |
18.00 0.00 |
|
15.0Cu0.7Ag0.3O/BSM/HG |
|
|
Bacillus cereus |
8.33 1.00 |
|
Staphylococcus aureus |
20.33 0.15 |
|
Tetracycline |
|
|
Bacillus cereus |
|
9.33 0.12 |
Staphylococcus aureus |
|
18.67 0.06 |
Figure 9 and Table 3 show the width of inhibition zone around discs with Cu0.7Ag0.3O/BSM/HG samples against bacterial strains after incubation for 24 h. There were no inhibition zones detected for BSM/HG films against Bacillus cereus and Staphylococcus aureus, whereas the tetracycline positive control was effective at 50 g/mL with inhibition zones of 9 19 mm. All Cu0.7Ag0.3O/BSM/HG samples showed effective antibacterial activities against all tested strains with inhibition widths ranging from 8 21 mm. Larger inhibition zones, 18 21 mm, were observed for Staphylococcus aureus, indicating that this bacterium was more sensitive than Bacillus cereus. Moreover, the 3.75 Cu0.7Ag0.3O/BSM/HG sample had the best performance, providing effective antibacterial activity with the lowest concentration of Cu0.7Ag0.3O. Cu0.7Ag0.3O particles with a minimum concentration of 3.75 mg/mL in a 3.75Cu0.7Ag0.3O/BSM/HG film showed the greatest antibacterial activities against Staphylococcus aureus and Bacillus cereus.
These findings suggest that the antibacterial performance of Cu0.7Ag0.3O/BSM/HG films is comparable to or better than some commercial hydrogel-based wound dressings containing silver or copper agents. For example, products such as Aquacel Ag and Acticoat Alobaid et al. [39] typically exhibit inhibition zones in the range of 10 – 20 mm against Gram-positive bacteria, similar to the 18 – 21 mm observed in this study. Moreover, the ability of the 3.75 Cu0.7Ag0.3O/BSM/HG sample to achieve these effects at low nanoparticle concentrations highlights the potential for reduced cytotoxicity and cost-effectiveness in clinical applications. These results support the feasibility of applying Cu0.7Ag0.3O/BSM/HG films as multifunctional wound dressings with enhanced antibacterial efficacy.
Although this study demonstrates promising antibacterial performance and swelling behavior of the Cu0.7Ag0.3O/BSM/HG films, cytotoxicity and biocompatibility assessments were not conducted and remain essential for clinical translation. Future work will focus on evaluating the in vitro and in vivo biocompatibility of the hydrogel films to ensure their safety and efficacy in wound healing applications.
Conclusions
This study demonstrates the successful synthesis and incorporation of Cu0.7Ag0.3O nanoparticles into basil seed mucilage (BSM)/hydrogel (HG) films for potential biomedical applications. The Cu0.7Ag0.3O composite exhibited the highest antibacterial activity, attributed to the synergistic effects of metallic Ag, Ag2O, and CuO phases confirmed by XRD and XPS analyses. Incorporating Cu0.7Ag0.3O into BSM/HG films led to a reduction in swelling capacity and tensile strength due to particle agglomeration, though the antibacterial performance against Staphylococcus aureus and Bacillus cereus remained exceptional, even at a low nanoparticle concentration of 3.75 mg/mL. The 0.5 % w/v BSM/HG film demonstrated superior mechanical and swelling properties, highlighting the critical role of BSM concentration in optimizing film performance. The uniform distribution of Ag and Cu particles within the hydrogel matrix was achieved, showcasing the effectiveness of the casting method for composite film fabrication.
This work represents a novel approach by combining a rarely studied natural biopolymer (BSM) with compositionally tunable Cu–Ag oxide nanoparticles, forming multifunctional hydrogel films with antibacterial properties not previously reported.
These findings underscore the potential of Cu0.7Ag0.3O-loaded BSM/HG films as multifunctional wound dressings with enhanced antibacterial properties. Future work should explore strategies to further improve the uniformity of particle dispersion to minimize agglomeration and maintain mechanical integrity. Additionally, investigations into the cytocompatibility and long-term stability of these films under physiological conditions will be essential for advancing their biomedical applications.
Acknowledgements
The authors would like to thank the Department of Chemistry, Faculty of Science, Udon Thani Rajabhat University (Thailand) for providing spectroscopy analysis. We also thank Professor Dr. Jeffrey C. Nash from the Office of Graduate Studies (Retired) of the Udon Thani Rajabhat University for his support in proofreading this manuscript.
Declaration of Generative AI in Scientific Writing
The authors used a generative AI tool (ChatGPT, OpenAI) solely for English grammar and language improvement. The scientific content, data interpretation, and conclusions were entirely developed by the authors.
CRediT Author Statement
Jiyapa Sripirom: Methodology, Data curation, Formal analysis, Writing- Reviewing and Editing.
Rungrudee Srisomang: Methodology, Reviewing and Editing.
Sakuntala Siri-Udom: Methodology, Reviewing and Editing.
Cybelle Morales Futalan: Methodology, Reviewing and Editing.
Khongvit Prasitnok: Methodology, Reviewing and Editing.
Orrasa Prasitnok: Methodology, Reviewing and Editing.
Sirilak Kamonwannasit: Methodology, Reviewing and Editing.
Agarat Kamcharoen: Methodology, Reviewing and Editing.
Pongtanawat Khemthong: Methodology, Reviewing and Editing.
Piaw Phatai: Conceptualization, Supervision, Writing- Reviewing and Editing, Project administration.
References
[1] V Brumberg, T Astrelina, T Malivanova and A Samoilov. Modern wound dressings: Hydrogel dressings. Biomedicines 2021; 9(9),1235.
[2] MB Labowska, K Cierluk, AM Jankowska, J Kulbacka, J Detyna and I Michalak. A review on the adaption of alginate-gelatin hydrogels for 3D cultures and bioprinting. Materials 2021; 14(4), 858.
[3] S Yue, H He, B Li and T Hou. Hydrogel as a biomaterial for bone tissue engineering: A review. Nanomaterials 2020; 10(8), 1511.
[4] H Zhang, Q Song, Z Deng, J Ren and X Xiang. Sodium alginate hydrogel toughened by guar gum for strain sensors. Polymer Bulletin 2024; 81, 8045-8056.
[5] ME Batouti, W Sadik, AG Eldemerdash, E Hanafy and HA Fetouh. New and innovative microwave-assisted technology for synthesis of guar gum-grafted acrylamide hydrogel superabsorbent for the removal of acid red 8 dye from industrial wastewater. Polymer Bulletin 2023; 80(5), 4965-4989.
[6] M Moradi, A Barati, S Moradi and E Zarinabadi. Synthesis and characterization of starch-based hydrogels containing myrtus oil nanoemulsion for wound dressings. Polymer Bulletin 2023; 80, 3043-3062.
[7] KGD Oznur and TDA Pınar. Statistical evaluation of biocompatibility and biodegradability of chitosan/gelatin hydrogels for wound-dressing applications. Polymer Bulletin 2024; 81, 1563-1596.
[8] G Nifontova, S Safaryan, Y Khristidis, O Smirnova, M Vosough, A Shpichka and P Timashev. Advancing wound healing by hydrogel-based dressings loaded with cell-conditioned medium: A systematic review. Stem Cell Research & Therapy 2024; 15(1), 371.
[9] R Jaiswal and AP Sherje. Recent advances in biopolymer-based smart hydrogel for wound healing. Journal of Drug Delivery Science and Technology 2024; 99, 105990.
[10] S Bashir, M Hina, J Iqbal, AH Rajpar, MA Mujtaba, NA Alghamdi, S Wageh, K Ramesh and S Ramesh. Fundamental concepts of hydrogels: Synthesis, properties, and their applications. Polymers 2020; 12(11), 2702.
[11] NP Esfahani, N Koupaei and H Bahreini. Fabrication and characterization of a novel hydrogel network composed of polyvinyl alcohol/polyvinylpyrrolidone/nano-rGO as wound dressing application. Journal of Polymer Research 2023; 30, 56.
[12] X Lin, X Zhao, C Xu, L Wang and Y Xia. Progress in the mechanical enhancement of hydrogels: Fabrication strategies and underlying mechanisms. Journal of Polymer Science 2022; 60(17), 2525-2542.
[13] Q Chen, H Chen, L Zhu and J Zheng. Fundamentals of double network hydrogels. Journal of Materials Chemistry B 2015; 3(18), 3654-3676.
[14] KO Rojek, M Cwiklinska, J Kuczak and J Guzowski. Microfluidic formulation of topological hydrogels for microtissue engineering. Chemical Reviews 2021; 122(22), 16839-16909.
[15] S Cometa, C Licini, MA Bonifacio, P Mastrorilli, M Mattioli-Belmonte and ED Giglio. Carboxymethyl cellulose-based hydrogel film combined with berberine as an innovative tool for chronic wound management. Carbohydrate Polymers 2022; 283, 119145.
[16] A Saarai, V Kasparkova, T Sedlacek and P Saha. On the development and characterisation of crosslinked sodium alginate/gelatine hydrogels. Journal of the Mechanical Behavior of Biomedical Materials 2013; 18, 152-166.
[17] K Yari, I Akbari and SAV Yazdi. Development and evaluation of sodium alginate-basil seeds mucilage beads as a suitable carrier for controlled release of metformin International Journal of Biological Macromolecules 2020; 159, 1-10.
[18] F Kurd, M Fathi and H Shekarchizadeh. Basil seed mucilage as a new source for electrospinning: Production and physicochemical characterization. International Journal of Biological Macromolecules 2017; 95, 689-695.
[19] N Srikhao, K Chirochrapas, N Kwansanei, P Kasemsiri, A Ounkaew, M Okhawilai, C Likitaporn, S Theerakulpisut and H Uyama. Multi-responsive optimization of novel pH-sensitive hydrogel beads based on basil seed mucilage, alginate, and magnetic particles. Gels 2022; 8(5), 274.
[20] S Nazir and IA Wani. Functional characterization of basil (Ocimum basilicum L.) seed mucilage. Bioactive Carbohydrates and Dietary Fibre 2021; 25, 100261.
[21] X Jing, H Mi, BN Napiwocki, X Peng and L Turng. Mussel-inspired electroactive chitosan/graphene oxide composite hydrogel with rapid self-healing and recovery behavior for tissue engineering. Carbon 2017; 125, 557-570.
[22] AA Mohammed, S Li, T Sang, JR Jones and A Pinna. Nanocomposite hydrogels with polymer grafted silica nanoparticles using glucose oxidase. Gels 2023; 9(6), 486.
[23] Y Kaptan, O Karal-Yilmaz, B Izbudak, B Giray, B Yilmaz and A Bal-Ozturk. Preparation of tetracycline hydrochloride loaded chitosan/silk fibroin/ZnO antibacterial biocomposite hydrogel sponges for wound healing application. Journal of Polymer Research 2023; 30, 49.
[24] A Martinez-Higuera, C Rodriguez-Beas, JMA Villalobos-Noriega, A Arizmendi-Grijalva, C Ochoa-Sanchez, E Larios-Rodriguez, JM Martinez-Soto, E Rodriguez-Leon, C Ibarra-Zazueta, R Mora-Monroy, HA Borbon-Nunez, A Garcia-Galaz, MDC Candia-Plata, LF Lopez-Soto and R Iniguez-Palomares. Hydrogel with silver nanoparticles synthesized by Mimosa tenuiflora for second-degree burns treatment. Scientific Reports 2021; 11, 11312.
[25] P Phatai and CM Futalan. Characteristics of cerium-aluminum-manganese mixed oxides and their performance in adsorbing methyl violet dye from an aqueous solution. Desalination and Water Treatment 2017; 62, 257-266.
[26] S Kamonwannasit, CM Futalan, P Khemthong, T Butburee, A Karaphun and P Phatai. Synthesis of copper-silver doped hydroxyapatite via ultrasonic coupled sol-gel techniques: structural and antibacterial studies. Journal of Sol-Gel Science and Technology 2020; 96(2), 452-463.
[27] FA Akgul, G Akgul, N Yildirim, HE Unalan and R Turan. Influence of thermal annealing on microstructural, morphological, optical properties and surface electronic structure of copper oxide thin films. Materials Chemistry and Physics 2014; 147(3), 987-995
[28] F Arshad, A Munir, QQ Kashif, TU Haq, J Iqbal, F Sher and I Hussain. Controlled development of higher-dimensional nanostructured copper oxide thin films as binder free electrocatalysts for oxygen evolution reaction, International Journal of Hydrogen Energy 2020; 45(33), 16583-16590.
[29] VDCG Videira, BN Harada, VG Vital, RAGD Silva, SPD Vasconcellos and DS Pellosi. Structural and antibacterial evaluation of copper, silver, and bimetallic silver/copper nanoalloys synthesized in chitosan biopolymer. Next Materials 2024; 3, 100071.
[30] V Sudha, G Murugadoss and R Thangamuthu. Structural and morphological tuning of Cu-based metal oxide nanoparticles by a facile chemical method and highly electrochemical sensing of sulphite. Scientific Reports 2021; 11, 3413.
[31] TC Kaspar, T Droubay, SA Chambers and PS Bagus. Spectroscopic evidence for Ag(III) in highly oxidized silver films by x-ray photoelectron spectroscopy. The Journal of Physical Chemistry C 2010; 114(49), 21562-21571.
[32] P Prieto, V Nistor, K Nouneh, M Oyama, M Abd-Lefdil and R Diaz. XPS study of silver, nickel and bimetallic silver–nickel nanoparticles prepared by seed-mediated growth. Applied Surface Science 2012; 258(22), 8807-8813.
[33] K Bialik-Was, KN Raftopoulos and K Pielichowski. Alginate hydrogels with aloe vera: The effects of reaction temperature on morphology and thermal properties. Materials 2022; 15(3), 748.
[34] H Wang, J Liu, X Fan, J Ren, Q Liu and B Kong. Fabrication, characterisation, and application of green crosslinked sodium alginate hydrogel films by natural crab-shell powders to achieve drug sustained release. LWT 2022; 171, 114147.
[35] Y Dong, D Sang, C He, X Sheng and L Lei. Mxene/alginate composites for lead and copper ion removal from aqueous solutions. RSC Advances 2019; 9(50), 29015-29022.
[36] W Lee and K Tsao. Effect of silver nanoparticles content on the various properties of nanocomposite hydrogels by in situ polymerization. Journal of Materials Science 2010; 45(1), 89-97.
[37] GR Deen and V Chua. Synthesis and properties of new “Stimuli” responsive nanocomposite hydrogels containing silver nanoparticles. Gels 2015; 1(1), 117-134.
[38] HA Ali and NJ Hameed. The study of the particle size effect on the physical properties of TiO2/cellulose acetate composite films. Journal of the Mechanical Behavior of Materials 2022; 31(1), 150-159.
[39] SA Alobaid, S Shrestha, M Tasseff, B Wang, MLV Hoek and PK Dutta. Activity of silver-zinc nanozeolite-based antibiofilm wound dressings in an in vitro biofilm model and comparison with commercial dressings. Discover Nano 2025; 20(1), 26.